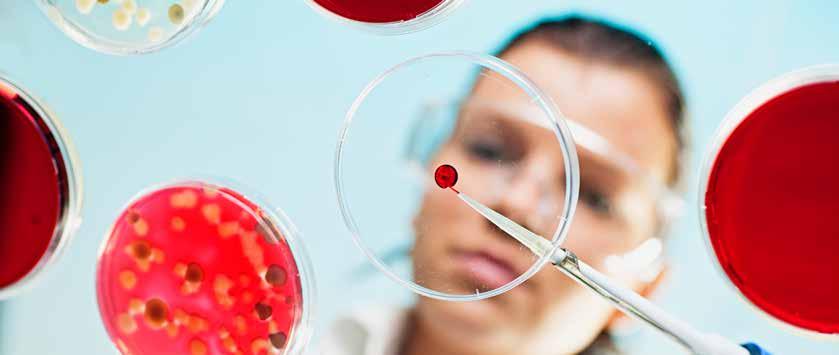

10 minute read
2.6 De kleinste organismen
Aan het eind van deze paragraaf kun je: • • • • uitleggen hoe eencellige organismen zich ongeslachtelijk voortplanten. uitleggen hoe een virus zich vermeerdert. uitleggen hoe een virus je ziek maakt. afmetingen van verschillende organismen en voorwerpen met elkaar vergelijken.
Bij deze paragraaf hoort de volgende practicumopdracht: • Gistcellen Overleg met je docent of je dit practicum gaat uitvoeren.
STARTOPDRACHT
1 Bacteriekolonies
Eén bacterie kun je met het blote oog niet zien, maar een kolonie van bacteriën wel. Zo’n kolonie van dezelfde bacteriën maak je door bacteriën bij een gunstige temperatuur op een voedingsbodem te laten delen.
Onderzoeksvraag: Op welke vinger(s) zitten de meeste bacteriën?
Dit heb je nodig: • • afgesloten petrischaal met voedingsbodem viltstift
Dit ga je doen: 1 Open de petrischaal. 2 Raak direct na opening de voedingsbodem aan, met alle vijf vingers op een verschillende plek. 3 Doe direct daarna het deksel weer op de petrischaal. 4 Zet je naam en klas op de onderkant van de petrischaal. 5 Zet de petrischaal op een warme plek. 6 Bekijk na een paar dagen het resultaat.
© Getty Images / E+ / poba
a Wat is je hypothese?
Beantwoord deze vraag voordat je het resultaat bekijkt!
Tel na zeven dagen het aantal kolonies en vul de tabel in.
Aantal kolonies duim wijsvinger middelvinger ringvinger pink
b Welke conclusie kun je trekken?
THEORIE
Onmisbare eencellige organismen
Om je heen leven veel organismen. Zelfs in en op je lichaam! Je kunt deze niet met het blote oog zien. De meeste van deze organismen zijn eencellig. Alle bacteriën zijn eencellig, maar er bestaan ook eencellige schimmels (zoals gisten), eencellige planten (zoals eencellige algen) en eencellige dieren (zoals amoeben) (zie figuur 1).
Eencellige organismen zijn heel belangrijk in de natuur. In je darmen leven vele miljoenen bacteriën die onmisbaar zijn voor het verteren van je voedsel. In de zee zorgen gigantische aantallen eencellige algen voor zuurstof en voedsel. Zij zijn het voedsel voor kleine diertjes, die op hun beurt weer gegeten worden door grotere dieren. Andere eencelligen zijn gisten en amoeben. De amoebe kan andere eencelligen opeten (zie figuur 2).
kok
bacil spirocheet
alg gist amoebe
Figuur 1 Eencellige organismen: drie typen bacteriën, een alg, een gist en een amoebe
De bacterie wordt waargenomen. De amoebe omcirkelt de bacterie. De amoebe breekt de bacterie af en eet hem op.
Figuur 2 Een amoebe eet een bacterie op.
Ongeslachtelijke voortplanting bij eencelligen
Net als bacteriën planten de meeste eencellige organismen zich voort door ongeslachtelijke voortplanting. De voortplanting gebeurt door celdeling en dat kan erg snel gaan. De eencellige schimmel gist kan zich onder ideale omstandigheden elke 90 minuten delen. Soms zijn de omstandigheden niet gunstig. Het kan bijvoorbeeld te koud of te warm zijn, of er is onvoldoende voedsel beschikbaar. Dan gaat de voortplanting van eencelligen veel langzamer. Ook zullen er tussendoor cellen sterven.
Virussen en virusbesmettingen
Naast eencellige organismen bestaan er ook virussen. Die zijn nóg veel kleiner dan bacteriën. Een virus vertoont geen levenskenmerken en is dus geen organisme. Een virus kan zich alleen vermeerderen in de cellen van een ander organisme.
Een virus kan in je lichaam terechtkomen door het bijvoorbeeld in te ademen of in te slikken. Het komt dan in contact met een lichaamscel. Wanneer het virus een lichaamscel binnendringt, is er een virusbesmetting. Daarna doorloopt het virus een aantal stappen om zich te vermeerderen (zie figuur 3).
In de cel valt het virus uit elkaar. Hierdoor komt het erfelijk materiaal van het virus vrij. Dit erfelijk materiaal geeft een paar opdrachten aan de binnengedrongen cel. Ten eerste moet de cel stoppen met het uitvoeren van zijn normale functie. Ten tweede moet de cel al zijn energie en stoffen gebruiken om nieuwe virussen te bouwen. De besmette cel wordt een soort ‘virusfabriek’.
Na verloop van tijd zit de cel zó vol met nieuwe virussen, dat de cel sterft. Dan komen alle nieuwe virussen vrij en kunnen zij andere cellen in de buurt binnendringen. Het hele proces herhaalt zich dan in de nieuw besmette cellen.
Veel virusbesmettingen veroorzaken ziekteverschijnselen. Van een besmetting met het waterpokkenvirus krijg je koorts en jeukende vochtblaasjes. Van een verkoudheidsvirus ga je hoesten en krijg je een verstopte neus. Het herpesvirus veroorzaakt een koortslip. Van het coronavirus kunnen sommige mensen behoorlijk ziek worden.

2. Virus hecht zich aan een celmembraan.

1. Virus wordt ingeademd. 3. Virus valt uit elkaar en erfelijk materiaal komt vrij.
4. Cel wordt een virusfabriek.
5. Cel sterft en virussen komen vrij.
Het coronavirus
Veel virussen besmetten alleen bepaalde dieren. Er is bijvoorbeeld het vogelgriepvirus en het virus dat bij katten de niesziekte veroorzaakt. Bij de vermeerdering van een virus ontstaan er soms veranderingen in het erfelijk materiaal. Dit kan tot gevolg hebben dat het virus sneller besmettingen veroorzaakt of van een dier overspringt op de mens.

Eind 2019 ontstond er zo’n verandering in een virus dat alleen bij een bepaald soort vleermuis voorkwam. Hierdoor kon het virus opeens ook de mens besmetten. Binnen een paar maanden was er een pandemie: het virus had zich over de hele wereld verspreid en maakte miljoenen mensen ziek. Dit virus is SARS-CoV-2, beter bekend als ‘COVID-19’ of het ‘coronavirus’.
© Shutterstock / r.classen
Het coronavirus SARS-CoV-2 dat wereldwijd grote gevolgen had.
Klein, kleiner, kleinst
Eencelligen kun je met het blote oog niet zien. Om een gistcel, eencellige alg of amoebe te bekijken, kun je een microscoop met een vergroting van 400x gebruiken. De meeste bacteriën en alle virussen zijn zo klein dat je ze zelfs met de maximale vergroting van 1000x maar met moeite kunt zien.
virus bacterie rode bloedcel amoebe kattenvlo pissebed muis
100 nm 1 µm 10 µm 100 µm 1 mm 10 mm 100 mm
1 nm = 1 nanometer = 0,001 µm 1 µm = 1 micrometer = 0,001 mm 1 mm = 1 millimeter = 0,001 m
Figuur 4 Microscopische verhoudingen. Elke stap naar rechts betekent 10x zo groot.
OPDRACHTEN
2 Een virusbesmetting
Een virus laat zich vermeerderen in een levende cel. Wanneer een virus een cel binnendringt, is de cel besmet.
In welke volgorde vinden virusbesmetting en virusvermeerdering plaats?
Zet de stappen in de juiste volgorde.
▢De cel gaat kapot en de nieuwe virusdeeltjes komen vrij.
▢De cel gaat virusonderdelen bouwen.
▢De cel krijgt opdracht om te stoppen met zijn normale taken.
▢De cel raakt overvol met virusdeeltjes.
▢Het virus koppelt zich aan het celmembraan.
▢Het virus valt uit elkaar, waarbij het erfelijk materiaal vrijkomt.
▢Het virus wordt opgenomen in de cel.
3 Voortplantende blauwalgen
In de zomer is er in Nederland wel eens een plaag van eencellige blauwalgen. Na een warme periode kan de hoeveelheid blauwalgen in meertjes en zwemplassen extreem toenemen. Het water wordt dan donkergroen. Dat noem je algenbloei. Het is gevaarlijk om in dat water te zwemmen. Blauwalgen maken namelijk gifstoffen. Als je in de algenbloei zwemt, kun je misselijk worden en huiduitslag krijgen. Bij warm weer worden buitenwateren daarom gecontroleerd.
Een watercontroleur neemt een watermonster uit een meertje en onderzoekt dit. Er zitten gemiddeld 5 blauwalgen per mL in. Het is zomer en de temperatuur van het water is 25 graden Celsius. Bij deze temperatuur delen de blauwalgen elke 30 minuten. Er is sprake van algenbloei als er minstens 1000 cellen per mL worden aangetroffen.
Bereken over hoeveel uur (afgerond naar beneden) er sprake is van algenbloei in de zwemplas waar de controleur het watermonster heeft genomen.
4 Hoe groot is dat?
In de foto zie je een aantal cellen, zoals je deze ziet door de microscoop op school. Maar hoe groot zijn die cellen nu eigenlijk? Dit kun je uitrekenen als je weet hoe breed het microscoopbeeld in werkelijkheid is. Als je die breedte deelt door het aantal cellen naast elkaar, krijg je de breedte van één cel.

© Shutterstock / Babul Hosen
Cellen door een microscoop bij 400x vergroting
In formule: breedte van één cel (in mm) = breedte van het microscoopbeeld (in mm) / aantal cellen naast elkaar
De breedte van de doorsnede van het beeld dat je bij een vergroting van 400x ziet, is 0,45 mm.
Hoe groot is de doorsnede van de cellen in de foto, uitgedrukt in mm?
5 Ongeslachtelijke voortplanting
Een bacterie plant zich ongeslachtelijk voort door middel van celdeling. Het DNA van de nakomelingen bevat geen mix van de eigenschappen van de ouders, maar is een kopie van de oorspronkelijke cel.
Bedenk wat voor de bacterie voor- en nadelen zijn van ongeslachtelijke voortplanting. Geef bij de volgende uitspraken aan of het een voordeel of een nadeel is voor bacteriën.
1 De bacteriën hebben geen individu van het andere geslacht nodig om zich voort te planten. Dit is een voordeel / nadeel van ongeslachtelijke voortplanting. 2 De bacteriën hoeven niet op zoek te gaan naar een partner. Dit is een voordeel / nadeel van ongeslachtelijke voortplanting. 3 De bacteriën krijgen geen nakomelingen met een mogelijk betere combinatie van eigenschappen. Dit is een voordeel / nadeel van ongeslachtelijke voortplanting. 4 De bacteriën geven foute eigenschappen onveranderd door aan hun nakomelingen.
Dit is een voordeel / nadeel van ongeslachtelijke voortplanting. 5 De bacteriën kunnen in korte tijd veel nakomelingen krijgen door deling. Dit is een voordeel / nadeel van ongeslachtelijke voortplanting.
6 ‘Grenzen aan de groei’
Eencellige organismen die zich ongeslachtelijk voortplanten, kunnen onder ideale omstandigheden enorm in aantal toenemen. Toch gebeurt dit niet zo snel in de natuur.
Welke factoren kunnen de toename van eencellige organismen in de natuur beperken?
☐de hoeveelheid beschikbaar voedsel ☐ ☐ ☐ de omgevingstemperatuur de aanwezigheid van roofdieren die eencellige organismen eten de aanwezigheid van virussen
7 Darmbacteriën
In je darmen zitten goedaardige darmbacteriën. Deze bacteriën helpen je bij het verteren van voedsel. Via ongeslachtelijke voortplanting groeit het aantal darmbacteriën. Maar toch raken je darmen niet overbevolkt met darmbacteriën. Tijdens het uitscheiden van vaste ontlasting (poep) verwijder je op een natuurlijke manier een deel van de darmbacteriën. De gemiddelde mens produceert ongeveer 175 gram vaste ontlasting per dag. Zo’n 30% van de vaste ontlasting bestaat uit darmbacteriën.
Bereken hoeveel gram darmbacteriën er gemiddeld per dag ontstaat in de darm via ongeslachtelijke voortplanting.
EXTRA OPDRACHTEN
8 Voortplantingssnelheid
Het record van snelste voortplanting staat op naam van de bacteriesoort Vibrio natriegens. Onder ideale omstandigheden kan deze bacterie zich elke 10 minuten delen. In de grafiek zie je hoe snel deze bacterie daardoor in aantal toeneemt.
1250
1000
750
aantal bacteriën
500
250
0
0
t in minuten
Toename Vibrio natriegens onder ideale omstandigheden
Bestudeer de grafiek. Op de X-as ontbreekt belangrijke informatie, want de tijdsduur (in minuten) is niet ingevuld.
Welk aantal minuten hoort er te staan op de plek waar nu een vraagteken staat? Laat dit met een berekening zien.
Ga uit van ideale groeiomstandigheden voor Vibrio natriegens. Bereken welk tijdstip (in minuten) onder de X-as moet staan waar nu het vraagteken staat.
9 Bacterie versus virus
Cellen kunnen op verschillende manieren beschermd worden tegen een succesvolle virusbesmetting.
•Een cel kan buiten het celmembraan met stoffen een blokkade vormen waar een virus niet doorheen kan. • Een cel kan erfelijk materiaal van een virus kapotmaken wanneer dit binnen in de cel aangetroffen wordt. • Een cel kan beschermd worden door speciale afweercellen die de cel te hulp schieten om virusdeeltjes in de omgeving weg te vangen.
Welke manieren kan een bacterie gebruiken om zich te beschermen tegen een succesvolle virusinfectie?
☐ ☐ ☐ een blokkade waar een virus niet langskomt de bescherming door speciale afweercellen het vernietigen van erfelijk materiaal van een virus
10 Formaat mitochondrium
Het mitochondrium is een bijzonder organel. Ooit waren mitochondriën vrij levende bacteriën. Lang geleden zijn deze vrij levende bacteriën in een andere cel gaan leven en na verloop van tijd veranderd in een organel.
De gemiddelde menselijke cel is ongeveer 100,0 µm (0,1 mm) groot.
Schat op basis van deze informatie hoe groot een mitochondrium is. Welke cel komt qua grootte het best daarmee overeen?
◯ de menselijke darmbacterie (2 µm (0,002 mm)) ◯ een eencellige alg (20,0 µm (0,020 mm)) ◯ een menselijke rode bloedcel (7,0 µm (0,007 mm)) ◯ het eencellige pantoffeldiertje (200,0 µm (0,200 mm))
Meer oefenen met de stof uit deze paragraaf? Kies online voor Herhaling of Plus.